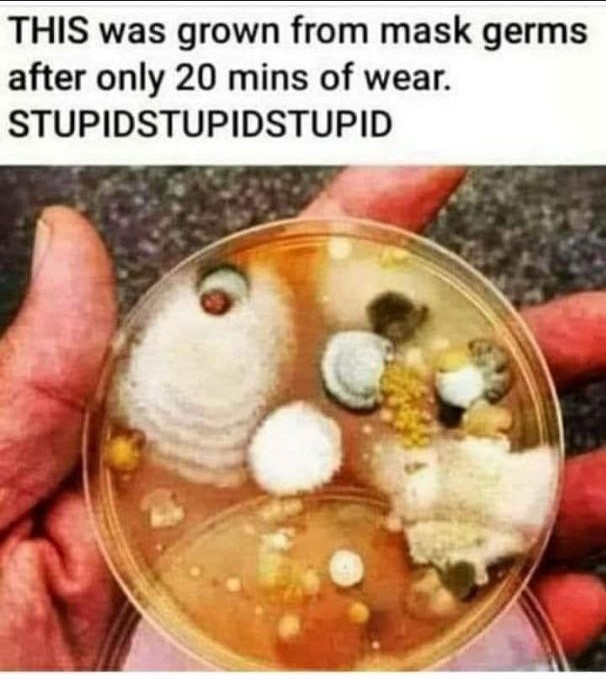

Warning: Some information and/or videos may contain sensitive and triggering content. Viewer discretion is advised.

https://open.spotify.com/episode/0aZte37vtFTkYT7b0b04Qz?si=632e7f23314747ee
https://open.spotify.com/episode/3SCsueX2bZdbEzRtKOCEyT?si=5d6c445431ad49cf
https://open.spotify.com/episode/43D9PMFx0j9BdbpcS9meBY?si=72a052bb97994cb4
https://open.spotify.com/episode/3DQfcTY4viyXsIXQ89NXvg?si=fb2a86584a1a4f4e
Proudly Powered by WordPress